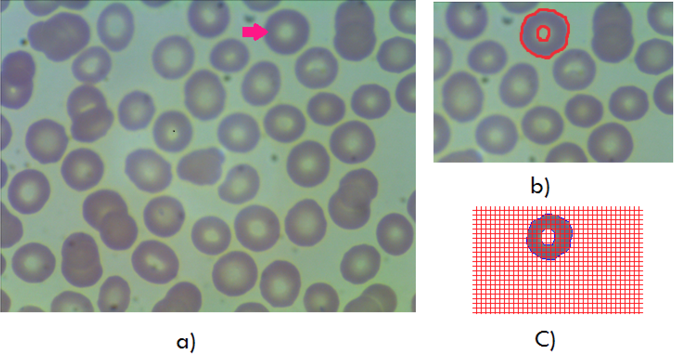
Figura1

Javier Oswaldo Rodríguez Velásquez1, María Yolanda Soracipa Muñoz2, Iván Andrés Ovalle Londoño3, Mónica Genith Castro Hernández4, Nairo Senejoa5, Bernardo Quijano Nieto6, Adriana Lizbeth Ortiz Tovar7, Esmeralda Esther Guzmán de la Rosa8, Arlyn Carolina Rozo Gonzalez9
1 MD. Director Grupo Insight, Centro de Investigaciones Clínica del Country. Bogotá, Colombia. Cra. 79B N° 51-16 Sur. Int. 5. Apto. 102, Bogotá D.C., Colombia. Teléfono: 4527541. Correo electrónico: grupoinsight2025@yahoo.es
2 Licenciada en Física. Investigadora Grupo Insight. Docente Escuela de Ciencias Básicas, Tecnología e Ingeniería ECBTI. Universidad Nacional Abierta y a Distancia UNAD. Bogotá, Colombia. Dirección: Calle 50 Nº 11A 72 sur; Teléfono: 3118852278; Correo electrónico: sitaroch@gmail.com
3 Filosofo. Investigador Grupo Insight, Centro de Investigaciones Clínica del Country. Bogotá, Colombia. Dirección: Carrera 80d # 49b-28s; Teléfono: 3219218672; Correo electrónico: ivaovallelo@unal.edu.co
4 MD. Msc. Salud Pública. Investigadora Grupo Insight, Centro de Investigaciones Clínica del Country. Dirección: Transversal 85G Nº24C-50 Interior 2 Apto 70 Barrio Modelia; Teléfono: 3012206063; Correo electrónico: monicagenith@gmail.com
5 MD. Hospital Militar. Dirección: Tv. 3 #49-00; Teléfono: 3134057252; Correo electrónico: njsenejoa@yahoo.es
6 MD. MD. Oftalmólogo subespecialista Vítreo y Retina. Oftalmocenter - Instituto de Mácula y Retina. Docente Universidad Nacional de Colombia. Docente Universidad Militar Nueva Granada. Teléfono: 7513449; Correo electrónico: baquijanon@unal.edu.co
7 Epidemióloga. Investigadora Grupo Insight. Bogotá, Colombia. Carrera 52 No. 174ª-48 Bogotá, Colombia. Teléfono: 3112660409. Correo electrónico: lizort@hotmail.com
8 MD. Msc. Gerencia. Investigadora Grupo Insight, Centro de Investigaciones Clínica del Country. Teléfono: 3084202; Correo electrónico: esmeralda.medica.unal@gmail.com
9 Estudiante Ingeniería ambiental. Universidad Abierta y a Distancias UNAD. Bogotá, Colombia. Dirección: Kr 78 F 42A 10 Sur; Teléfono: 3102160305; Correo electrónico: arlyncarol@gmail.com
Archivos de Medicina (Manizales), Volumen 18 N° 1, Enero-Junio 2018, ISSN versión impresa 1657-320X, ISSN versión en línea 2339-3874. Rodríguez Velásquez J.O.; Soracipa Muñoz M.Y.; Ovalle Londoño I.A.; Castro Hernández M.G.; Senejoa N.; Quijano Nieto B.; Ortiz Tovar A.L.; Guzmán De La Rosa E.E.; Rozo González A.C.
Recibido para publicación: 13-11-2018 - Versión corregida: 29-03-2018 - Aprobado para publicación: 15-05-2018
Rodríguez-Velasquez JO, Soracipa-Muñoz MY, Ovalle-Londoño IA, Castro-Hernández MG, Senejoa N, Quijano-Nieto B, et al. Geometría fractal aplicada para comparar los espacios ocupados por eritrocitos normales y esferocitos. Arch Med (Manizales) 2018; 18(1):13-23. DOI: https://doi.org/10.30554/archmed.18.1.1835.2018
Objetivo: desarrollar una nueva metodología que evalúe la forma del eritrocito normal y el esferocito a partir de los espacios ocupados por cada uno de ellos, medido con el método de Box Counting. Materiales y métodos: se analizaron 20 imágenes de extendido de sangre periférica, en las cuales se observaron un gran número de eritrocitos normales y esferocitos. Se superpusieron dos rejillas Kp de 5 x 5 pixeles y Kg de 10 x 10 pixeles, para calcular el espacio ocupado por dos regiones del eritrocito normal las cuales son, el disco y centro de este visto de manera frontal, así como el espacio ocupado por el esferocito mediante el método de Box Counting. Resultados: los espacios ocupados por el exterior e interior del eritrocito normal con la rejilla Kp variaron entre 47 y 59, y entre 8 y 16, respectivamente. En cambio, los espacios ocupados por los esferocitos variaron entre 25 y 36. Las proporciones entre la superficie y los valores de la rejilla Kp, de las regiones del eritrocito normal variaron entre 9,250 y 32,24, y para los esferocitos variaron entre 34,63 y 71,39. Conclusiones: las alteraciones en la forma del eritrocito normal pueden ser diferenciadas mediante los rangos hallados para el espacio ocupado por la superficie y las proporciones S/Kp de cada una de las regiones del eritrocito a partir de las nociones de la geometría fractal y euclidiana.
Palabras clave: fractales, hematología, eritrocito, anemia hemolítica.
Objective: to develop a new methodology that evaluated the shape of the normal erythrocyte and the spherocyte from the spaces occupied by each one, as measured by the Box Counting method. Materials and methods: 20 images of peripheral blood smear were analyzed, in which a large number of normal erythrocytes and spherocytes were observed. Two Kp grids of 5 x 5 pixels and 10 x 10 pixels Kg were superimposed to calculate the space occupied by two regions of the normal erythrocyte which are, the disk and center of the latter, viewed frontally, as well as the occupied space by the spherocyte using the Box Counting method. Results: The spaces occupied by the exterior and interior of the normal erythrocyte with the Kp grid varied between 47 and 55, and between 8 and 16, respectively. In contrast, the spaces occupied by the spherocytes varied between 25 and 36. The proportions between the surface and the values of the K grid of the normal erythrocyte regions varied between 9.250 and 32.24, whereas the spherocytes varied between 34,63 and 71,39. Conclusions: alterations in the shape of the normal erythrocyte can be differentiated by the ranges found for the space occupied by the surface and the proportions S/Kp of each of the erythrocyte regions from the notions of fractal and Euclidean geometry.
Keywords: math, fractals, hematology, erythrocyte, anemia hemolytic.
En geometría un objeto regular en un plano posee dos dimensiones y en el espacio tres dimensiones. En cambio, si el objeto presenta una forma irregular, esta puede ser medible mediante la geometría fractal calculando para ello la dimensión fractal [1], en esta geometría el objeto recibe el nombre de fractal. Los diferentes fractales provienen de dos grandes grupos, los fractales deterministas que pueden ser algebraicos o geométricos, como por ejemplo la trayectoria de un péndulo; los indeterministas (o estocásticos) como los objetos de la naturaleza denominados salvajes [2]. La generación de estos últimos fractales implica la introducción de parámetros aleatorios, los cuales buscan una semejanza con los objetos de la naturaleza, que se caracterizan por modificaciones e irregularidades en su estructura [3,4].
Para cada tipo de fractal, existe un método matemático que permite calcular el grado de irregularidad, denominado dimensión fractal. En el caso del fractal salvaje, la irregularidad es calculada mediante el método de Box-Counting [2]. Este método permite calcular la distribución espacial del fractal, que se puede observar a diferentes escalas mediante la superposición de cuadrículas o rejillas con distinta dimensión.
Los hematíes pueden ser observados mediante el microscopio a partir de técnicas de tinción como son las de Wright y Romanowsky [5]. El eritrocito normal presenta una forma bicóncava, cuyo diámetro varía entre 7µm y 9 µm. En el momento de observar variaciones en las características anteriormente mencionadas, se considera la muestra de extendido de sangre periférica como anormal, la cual puede estar posiblemente asociada a una enfermedad [6]. La primera descripción de hematíes de forma esférica fue denominada microcitos [7]. Posteriormente, se observó que la morfología de los eritrocitos se puede caracterizar según se produzca una ganancia o pérdida de superficie o de volumen [8]. Los esferocitos se caracterizan por una disminución de la relación superficie/volumen [8]. Sin embargo, aún continúa siendo un problema clásico en la biología celular, la comprensión de estas alteraciones en la morfología de los eritrocitos. Problema que en las últimas cuatro décadas también ha atraído la atención de los físicos [9].
En los marcos de las observaciones anteriores, el diseño de nuevas metodologías fundamentadas desde la perspectiva de la física y la matemática, han logrado caracterizaciones más precisas de las alteraciones morfológicas de los glóbulos rojos aplicando para ello la geometría fractal y euclidiana [11-14]. Las alteraciones leves en la membrana eritrocitaria, no observables en un eritrocito normal, pueden ser caracterizadas mediante la geometría fractal [10]. A partir de esta geometría, fue posible evaluar otras alteraciones en la morfología de los glóbulos rojos en extendido de sangre periférica, mediante la geometría euclidiana y fractal, hallando nuevas relaciones morfométricas entre las proporciones de la superficie y borde de la estructura del eritrocito, lo cual permitió establecer diferencias cuantitativas entre eritrocitos normales respecto a las distintas alteraciones de su forma [11]. Adicionalmente todas las posibles alteraciones morfológicas del eritrocito, fueron evaluadas a partir de una simulación teórica [12]. En un estudio reciente, se desarrolló una metodología que logró caracterizar el espacio ocupado por la superficie y borde de la parte interior y exterior de un eritrocito normal al ser este observado de manera frontal, estableciendo rangos de valores en los cuales pueden variar los eritrocitos normales en relación a los espacios ocupados por su parte interior y exterior [13]. Así mismo, se realizó un estudio que diferencia los equinocitos según su grado de irregularidad [14], más no por el número de espículas cortas con extremos romos descritas convencionalmente [6].
La presente investigación tiene como propósito realizar una inducción matemática para caracterizar de forma conjunta la morfología del eritrocito normal y el esferocito, con el fin de establecer parámetros matemáticos diferenciadores, midiendo su superficie y contorno en el contexto de la geometría euclidiana y fractal en el espacio de Box Counting.
Método de Box Counting: cálculo matemático aplicado en fractales salvajes para hallar su dimensión fractal, en el presente estudio la estructura del eritrocito normal y el esferocito, se encuentra dentro los fractales salvajes; donde K: el grado de partición de la cuadrícula, N: es el número de espacios que contiene el contorno del objeto y D: la dimensión fractal (15).

Ecuación 1
Regiones de la estructura de un eritrocito normal: la región uno (R1) representa la parte exterior y la región dos (R2) corresponde a la parte central del eritrocito al ser observado de manera frontal.
Rejillas: consiste en una cuadrícula con dimensiones de 5x5 y 10x10 pixeles. En donde la cuadricula de 5x5 pixeles, se denomina rejilla de cuadros pequeños (Kp) y la cuadrícula de 10x10 pixeles, rejilla de cuadros grandes [10-14].
S (superficie en píxeles): La superficie en píxeles del esferocito y de las R1 y R2 del eritrocito normal, se establece a partir del número de píxeles que tocan el interior o el borde de la imagen medida.
Procedimiento
Se tomó para el estudio 20 imágenes de extendido de sangre periférica, 10 de las cuales fue observado un gran número de eritrocitos normales y 10 con un gran número de esferocitos. Estas imágenes fueron reconocidas por el especialista del Laboratorio de referencia en Morfología Hematológica, según los parámetros de laboratorio convencionales. Las imágenes caracterizadas en el presente estudio, hacen parte de un archivo de muestras de sangre periférica del laboratorio y fueron donadas para fines investigativos.
La técnica de tinción utilizada para observar los eritrocitos fue Romanowsky [5]. El microscopio utilizado fue Carl Zeiss con un objetivo de 10x y un aumento ocular de 100x, las imágenes de los eritrocitos normales y esferocitos fueron tomadas por una Cámara de microscopio digital. Posteriormente, las imágenes fueron editadas en Microsoft Office Professional Plus 2010, con el fin de dejar todas las imágenes con una dimensión de 448 x 336 pixeles.
Se realizó una inducción matemática, la cual consiste en escoger pocos casos representativos de dos estados altamente diferenciables uno respecto del otro. En el presente estudio la inducción matemática fue realizada en la estructura de cinco eritrocitos normales y cinco esferocitos. A partir de los resultados de la inducción se busca establecer valores matemáticos característicos de ambas estructuras.
A continuación, fue delineado el contorno de las imágenes de los eritrocitos normales y los esferocitos seleccionados para la inducción matemática (ver figura 1 y 2). Seguidamente, fue superpuesta las dos rejillas (ver definiciones), para evaluar mediante el método de Box Counting el espacio ocupado por la R1 y R2 del eritrocito normal (ver Figura 1) y de esta manera hallar su dimensión fractal. Paralelamente fue realizó este mismo procedimiento con los esferocitos (ver Figura 2). A partir del análisis de los resultados se observó que la rejilla que permite establecer diferencias morfológicas normales, así como para todas las alteraciones de los eritrocitos es la rejilla Kp, tal y como se hizo en las dos metodologías previamente desarrolladas por Rodríguez y col [10,11]. De forma semejante se procedió con los eritrocitos normales y esferocitos que no fueron seleccionados para la inducción matemática.
Figura 1. Imagen de extendido de sangre periférica en la cual se puede observar gran número de eritrocitos normales. a) La flecha indica un eritrocito normal el cual fue posteriormente delineado; b) eritrocito normal al cual fue delineado la R1 y R2; c) superposición de rejilla de 5 x 5 pixeles en la R1. Fuente: autores.
Figura 2. Imagen de un extendido de sangre periférica en el cual se encuentra como ejemplo algunos de los esferocitos medidos. a) y d) Esferocitos al que fue delineado su contorno; b) y e) Esferocito delineado y separado del resto de la muestra; c) y f) Superposición de la rejilla Kp de 5 x 5pixels en los esferocitos delineados y separados del resto de la imagen. Fuente: autores.

Finalmente fueron comparados los resultados de la inducción matemática con los resultados de los eritrocitos normales y esferocitos no seleccionados para la inducción matemática, con el fin de establecer valores matemáticos característicos de estas dos estructuras. El tiempo empleado para seleccionar las imágenes fue de dos semanas, medirlas y luego realizar los cálculos matemáticos fue de una semana.
Este trabajo cumple con las normas éticas, científicas, técnicas y administrativas para la investigación en salud, basada en la resolución No. 008430 de 1993, y específicamente con el Título II, Capitulo 1, artículo 11 en inciso a, el cual hace referencia a la investigación sin riesgo en seres humanos, dado a que se hizo cálculos matemáticos en muestras de sangre del laboratorio clínico donador de las imágenes, cuyos resultados no implican la intervención directa sobre los pacientes. Adicionalmente, cumple con los principios éticos de la Declaración de Helsinki de la Asociación Médica Mundial.
Los resultados de la inducción matemática realizada en los eritrocitos normales, establece que los espacios ocupados por la R1 calculados con la rejilla Kp varío entre 47 y 59, con la rejilla Kg entre 22 y 32. La dimensión fractal para la R1 vario entre 0,88 y 1,10, para la R2 varió entre 0,87 y 1,22. Al observar los resultados de la dimensión fractal, se puede evidenciar que estos valores no permiten caracterizar y establecer diferencias entre las regiones evaluadas del eritrocito normal (ver Tabla 1). La superficie de la R1 varío entre 987 y 1612, y entre 74 y 267 para la R2 (Ver tabla 1).
Tabla 1. Medidas representativas de la región uno (R1) y dos (R2) de 8 de 60 eritrocitos normales delineados. Donde Kp: es en número de cuadros ocupados por las regiones R1 y R2 establecidas al superponer la rejilla de 5 x 5 pixeles. Kg: es en número de cuadros ocupados por las regiones R1 y R2 al superponer la rejilla de 10 x 10 pixeles. Df: es la dimensión fractal; S: superficie. S/Kp: proporción entre la superficie y el número ocupados con la rejilla Kp. El término I1R1 y I2R1, representa los resultados de la inducción matemática para la región R1

Fuente: autores.
Los resultados de la inducción matemática realizada en los esferocitos, establece que los espacios ocupados por los esferocitos con la rejilla Kp variaron entre 25 y 36, con la rejilla Kg entre 12 y 18 (ver Tabla 2). La dimensión fractal de los esferocitos varió entre 0,74 y 1,70 (ver tabla 2), a partir de estos resultados también se observa que las dimensiones fractales al ser comparadas no permiten establecer diferencias y caracterizar la estructura de los esferocitos. Los valores para la superficie de los esferocitos vario entre 880 y 1999.
Tabla 2. Medidas representativas de 10 de 50 esferocitos delineados. Donde Kp: es el número de cuadros ocupados por el esferocito al superponer la rejilla de 5 x 5 pixeles. Kg: es el número de cuadros ocupados por el esferocito al superponer la rejilla de 10 x 10 pixeles. Df: es la dimensión fractal; S: la superficie. S/Kp: proporción entre la superficie y el número ocupados con la rejilla Kp. Los términos I1esf y I2esf representan los resultados de la inducción matemática de los eferocitos.

Fuente: autores.
Los cálculos de las proporciones entre S/Kp para la R1 varió entre 24,58 y 32,24, para la R2 entre 9,25 y 17,80. Para los esferocitos las proporciones entre S/Kp variaron entre 35,20 y 71,39 (Ver tablas 1 y 2).
De los anteriores resultados se puede observar que los espacios ocupados por los eritrocitos normales y los esferocitos, pueden ser caracterizados y diferenciados a partir del valor mínimo y máximo calculado para la R1 y esferocito al superponer la rejilla Kp, es decir, el rango de valores {47-59} y {25-36} respectivamente. Más aún, los valores de las proporciones S/Kp muestran que el rango de los esferocitos {35,20-71,39}, se encuentra por fuera del rango de la R1 {21-32,24}. En efecto, estos nuevos rangos de valores evidencian la posibilidad de realizar distinciones más precisas entre los eritrocitos normales y los esferocitos.
Discusión
Este es el primer trabajo en el que se desarrolla una inducción matemática en el área de la hematología, la cual permite caracterizar de forma objetiva y reproducible la estructura del eritrocito normal y el esferocito. La metodología geométrica aplicada en el presente estudio evidencio que los espacios ocupados por la superficie exterior del eritrocito normal y los espacios ocupados por la superficie del esferocito, analizada en el contexto de la geometría fractal, permiten establecer diferencias cuantitativas entre estas dos estructuras. Esto fue posible a partir del establecimiento de un orden matemático hallado mediante la superposición de la rejilla Kp y el cálculo de la proporción S/Kp, para los eritrocitos normales y los esferocitos.
El presente estudio refina los resultados establecidos en estudios anteriores a partir de la inducción matemática [10-12]. Adicionalmente, los primeros estudios revelan lo adecuado que resulta hacer caracterizaciones matemáticas y físicas de la estructura de los eritrocitos normales y sus diferentes alteraciones en la forma, en razón de los principios de la geometría fractal y euclidiana. Cabe agregar, que los resultados establecidos en este estudio abren el camino para hacer distinciones matemáticas más precisas de los esferocitos, en razón a que los rangos de los esferocitos son menores en comparación con los rangos establecidos para la R1 de los eritrocitos normales. De forma semejante se puede hacer con los valores de las proporciones S/Kp, lo cual evidencia que son estos valores los que permiten establecer diferencias matemáticas y no los valores de la dimensión fractal tal y como se ha evidenció en estudios posteriores [10-14]. Este método contribuye a realizar medidas de forma más precisa, en particular en aquellas alteraciones que estén indicando indicios de alguna patología.
La presente investigación aporta un nuevo sistema de medida que contribuye en la comprensión de la estructura del eritrocito cuando este es normal, y sus posibles alteraciones de su forma como es el caso de los esferocitos. En un estudio reciente [13], se estableció el primer rango de valores en el cual puede variar la R1 y R2 del eritrocito normal a partir de la superposición de la rejilla Kp, estos valores fueron de {47-56} para la R1 y para la R2 de {9-14}, cuyo valor de las proporciones vario entre la S/Kp 22,79 y 32,35 para la R1, y entre 9,111 y 18,31 para la R2 [13]. Adicionalmente, se puede observar como los resultados hallados en el anterior estudio se encuentran dentro de los valores establecidos a partir de la inducción matemática; más aún, el espacio ocupado por el esferocito y la R1 del eritrocito normal calculado a partir de la superposición de la rejilla Kp y los valores de las proporciones S/Kp, permiten hacer distinciones matemáticas entre ambas estructuras, y no los valores de la dimensión fractal conforme se ha evidenciado en otros estudios [10-14].
La metodología aplicada en el presente estudio, contribuye al especialista a realizar mejores reconocimientos en las diferentes alteraciones de los eritrocitos, en vista que está evaluando la estructura real del eritrocito, evitando realizar caracterizaciones basadas en simulaciones de estas estructuras, que en la mayoría de los casos se alejan de la realidad misma del objeto medido. Más aún puede contribuir como herramienta de ayuda diagnóstica, para un tipo de patología especifica. Adicionalmente, los resultados del estudio reconceptualiza los parámetros visuales que debe considerar el experto al ver el extendido de sangre periférica, en relación a los eritrocitos normales los cuales se caracterizan por que en ellos se puede hacer una analogía de centros y forma “circular” que les permite diferenciarse de las demás estructuras eritrocitarias. De esta manera la noción de esfera y circularidad atribuidas a los eritrocitos fue reformulada en este estudio fundamentado en el contexto de la geometría fractal e euclidiana.
Las metodologías previamente desarrolladas para evaluar las estructuras eritrocitarias normales y sus alteraciones, han logrado como en otros estudios realizados en células de cuello uterino [16,17] y arterias coronaria [18] medidas el espacio de Box Counting, evidenciar lo adecuado que resulta analizar las alteraciones en las formas de estas estructuras desde las nociones de la geometría fractal y euclidiana, para establecer parámetros diferenciadores aún en los casos en que las medidas clínicas estén limitadas, como en el caso del sistema Bethesda el cual estable un grupo de células denominadas células escamosas atípicas de significado indeterminado ASCUS [16].
La estructura de los eritrocitos y sus cambios, han sido descritos mediante las nociones de la geometría euclidiana, que asocian la forma de los eritrocitos con figuras geométricas como son un disco cóncavo, esfera y elipse [6, 19, 20]. A partir de estas nociones se han diseñado nuevos estudios con el propósito de hacer comparaciones cualitativas, a partir de modelos computacionales aplicando la parametrización esférica de armónicos [21]. El proceso de modelación consiste en encontrar la superficie que “mejor se ajuste” a la forma de un glóbulo rojo y sus alteraciones a partir de imágenes en 3D. El estudio busca el establecimiento de respuestas cuantitativas a las alteraciones de los eritrocitos, mediante la superficie que mejor se ajuste, a una alteración específica del eritrocito. Es un estudio que refina estudios previos y mejora los bancos de datos de imágenes, con los cuales se puedan posteriormente hacer más comparaciones que se ajusten o mejoren las medidas ya encontradas. Sin embargo, es tipo de asociaciones resultan a menudo insuficientes para hacer distinciones precisas en la variación de un eritrocito, cuando el objetivo es evaluar la efectividad y adversidades de un tratamiento terapéutico [22], ya sea este por radiación de rayos X [23], durante y después de la infección de la malaria [24].
El presente estudio en cambio cuantifica las características morfológicas del eritrocito normal y el esferocito, desde el espacio ocupado por ambos analizando estos resultados desde la perspectiva de la geometría fractal y su relación con las nociones de la geometría euclidiana, de forma semejante a como ya se ha hecho con otras estructuras como son “la” arterial, células de cuello uterino y en el ventrículo izquierdo [16-18,25]. También, resulta oportuno resaltar que el fenómeno de alteración eritrocitaria se observa de forma no continua sino discreta. Por lo tanto, obedece a la noción de ventana temporal establecido por Prigogine [26], que en esta investigación corresponde a un fenómeno acausal, cuya finalidad se centra en el establecimiento de órdenes matemáticos subyacentes a la estructura del eritrocito normal independientemente de cualquier análisis poblacional, siendo posible contrastarlos en cada caso particular.
En el marco de los estudios desarrollados en el contexto de teorías físicas y matemáticas, se encuentran metodologías de aplicación clínica que han proporcionado soluciones en otros ámbitos de la medicina. Se han realizado predicciones del comportamiento de la dinámica cardiaca de adulto [27], neonatal [28], y casos de mortalidad [29]. Se han desarrollado predicciones de brotes de malaria en 820 municipios de Colombia en rangos de tres semanas, con un 99,86% de efectividad [30]. También, se han desarrollado métodos predictivos en inmunología [31], biología molecular [32] e infectología [33].
En vista de la base teórica, matemática y geométrica que sustentan la presente metodología, es necesario hacer pruebas con mayores números de imágenes para confirmar la capacidad diagnóstica de la metodología, debido a que no existe un software capaz de realizar este tipo de medidas, lo que dificulta la aplicación clínica de la metodología. Se plantea a futuro realizar tecnología que permita realizar este tipo de mediciones.
Agradecimientos
Agradecemos a la Universidad Militar Nueva Granada, por su apoyo a nuestras investigaciones. Especialmente a la Vicerrectoría de Investigaciones y la Facultad de Medicina. Extendemos un agradecimiento especial a la Dra. Nydia Alexandra Rojas, Directora de Investigaciones de la Facultad de Medicina, al Dr. Jorge Luque, Decano de la Facultad de Medicina, a la Dra. Yanneth Méndez, Vicerrectora académica y a la Ing. Marcela Iregui, Vicerrectora de Investigaciones.
Un agradecimiento especial a la Dra. Beatriz Amaya Directora del Laboratorio de referencia en Morfología Hematológica, por su apoyo a nuestras investigaciones. Agradecemos a los docentes de la Escuela de Ciencias Básicas, Tecnología e Ingeniería de la Universidad Nacional Abierta y a Distancia. Adicionalmente, agradecemos al Centro de Investigaciones de la Clínica del Country, a los Doctores Tito Tulio Roa, Director de Educación Médica, Jorge Ospina, Director Médico, Alfonso Correa, Director del Centro de Investigaciones, por apoyar durante años a nuestras investigaciones.
Conflictos de interés: ninguno.
Fuente de Financiación: este artículo es producto del proyecto “Evaluación física y matemática de variables hemodinámicas de pacientes de la Unidad de Cuidados Intensivos fundamentada en la geometría fractal y los sistemas dinámicos: Cuantificaciones de aplicación clínica en 14 horas”; desarrollado en el Centro de Investigaciones de Clínica del Country, en alianza con la Universidad Militar Nueva Granada.
Dedicatoria
A nuestros hijos
Literatura citada
